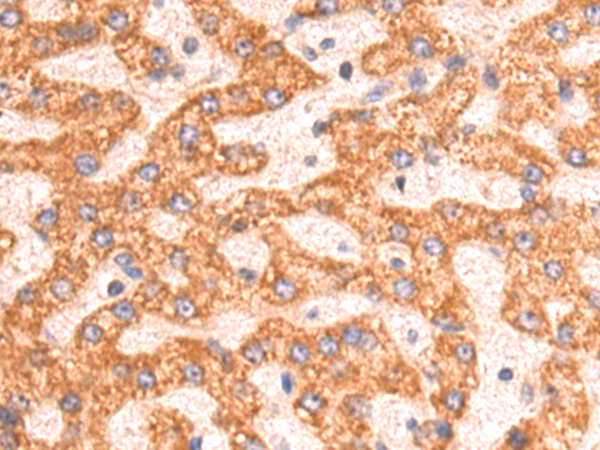
Rabbit Polyclonal Antibody to HMGCL
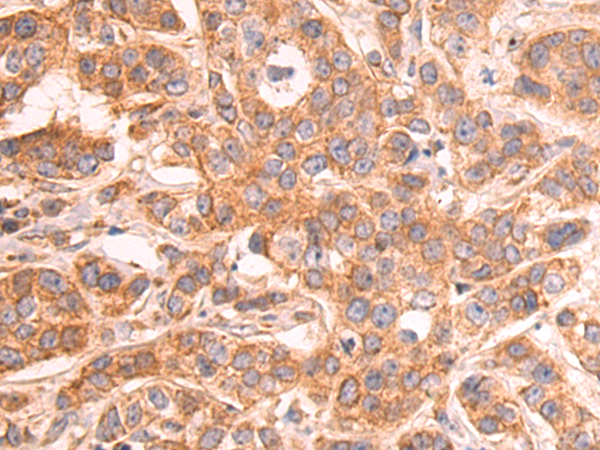
Rabbit Polyclonal Antibody to HMGCL

提醒成功

搜索
Rabbit Polyclonal Antibody to HMGCL
-
货号:
P08401 -
别名:
HL -
应用:
WB,IHC -
反应种属:
Human, Mouse, Rat -
抗体类型:
Primary antibody -
Swissprot:
P35914 -
规格:
-
数量:
-+ -
说明书:
目录价¥1980

Rabbit Polyclonal Antibody to HMGCL
Description |
|---|
The protein encoded by this gene belongs to the HMG-CoA lyase family. It is a mitochondrial enzyme that catalyzes the final step of leucine degradation and plays a key role in ketone body formation. Mutations in this gene are associated with HMG-CoA lyase deficiency. Alternatively spliced transcript variants encoding different isoforms have been found for this gene. |
Specification |
|
|---|---|
| Aliases | HL |
| Swissprot | P35914 |
| WB Predicted band size | 34 kDa |
| Host/Isotype | Rabbit IgG |
| Antibody Type | Primary antibody |
| Storage | Store at 4°C short term. Aliquot and store at -20°C long term. Avoid freeze/thaw cycles. |
| Species Reactivity | Human, Mouse, Rat |
| Immunogen | Fusion protein of human HMGCL |
| Formulation | Purified antibody in PBS with 0.05% sodium azide and 50% glycerol. |
Application |
|
|---|---|
| WB | 1/1000-1/5000 |
| IHC | 1/50-1/200 |
| ELISA | 1/5000-1/10000 |
Product Image
- Gel: 8%SDS-PAGE, Lysate: 40 μg, Lane 1-3: Mouse brain tissue, Mouse fetal tissue, Mouse adrenal gland tissue lysates, Primary antibody: P08401(HMGCL Antibody) at dilution 1/1200, Secondary antibody: Goat anti rabbit IgG at 1/5000 dilution, Exposure time: 1 second
- The image is immunohistochemistry of paraffin-embedded Human liver cancer tissue using P08401(HMGCL Antibody) at dilution 1/75. (Original magnification: ×200)
- The image is immunohistochemistry of paraffin-embedded Human breast cancer tissue using P08401(HMGCL Antibody) at dilution 1/75. (Original magnification: ×200)
For Reseach Only
Application Key:WB - Western Blot | IHC - Immunohistochemistry | ICC - Immunocytochemistry | FCM - Flow Cytometry | ELISA - Enzyme-linked Immunosorbent Assay | IP - Immunoprecipitation
#P08401

相关产品















 微信/QQ登录
微信/QQ登录


 首页
首页